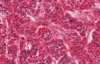
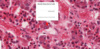
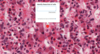
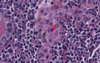
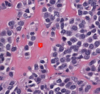
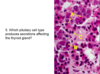

Endo Histo Flashcards
(121 cards)
zones of the cortex?
outside - inside
zona glomerulosa
zona fasiculata
zona reticulatis
The cortex does not have its own venous supply so hormones from the cortex will drain through the medulla to arrive at that central vein. They can and do influence the medulla.

pituitray acinus
This round arrangement of anterior pituitary cells is an acinus.
Normal adenohypophysis is composed of small acini of pituitary cells surrounded by an intact reticulin network (a). In hyperplasia, the acinar architecture is maintained and the reticulin network is preserved, but the acini are increased in size ( b). In contrast, pituitary adenomas are characterized by complete disruption of the reticulin fiber network ( c). Immunohistochemical stains are required to determine the hyperplastic cell population, and these stains will identify the admixed normal cells that contain all of the normal adenohypophysial hormones.
parathyroid

There is more fat in the parathyroid with increasing age.
delta cells
secrete somatostatin
inhibit glucagon and insulin
few

pars distalis vs pars nervosa - how to tell the difference
pars distalis is much more cellular than the pars nervosa


cromaffin cells - direct input from sympatehtic neurons
adrenal medulla
cortical hormones inhibit axonal growth in vivo
This is called a chromaffin stain. The cells have an affinity for dichromate and that’s why they stain this way. This identifies them as a neural crest derivative and they have a unique feature which is that they actually are like post-synaptic neurons. Sympathetic nervous system cells actually synapse directly with cells in the medulla. Whereas cells in the cortex are again producing precursors which will be released when the cortex is stimulated by ACTH. The medulla stores the active hormone and the hormones released by the medulla are epinephrine and norephinephrine—the fight or flight response. These can be released immediately and I’m sure you have felt their effects, postive or negative. You will feel your heartbeat/RR immediately increase. Will shut down blood vessels to your gut, dilate blood vessels to skeletal muscles and brain. Secreted directly into the bloodstream rather than having to first be converted to become active.


psomma body
papillary carcinoma
Psammoma body: calcified structures (tumor cell necrosis)

parathyroid
adipocyte
insulinoma
neuroendocrine tumor
beta cell origin
circumscribed by a fibrous capsule
excess insulin causes hypoglycemia
90% benign

beta cells
secrete insulin stimulating glucose uptake by muscle and fat cells and fat storage


delta cells
least
secrete somatostatin

cd8
CD4, B, Plasma cells but the thing you have the most is cytotoxic CD8 t cells!

D
medulla
thyroid

thyroid adenoma
The thyroid adenoma follicles directly resemble the normal thyroid gland epithelium. It is a clonal proliferation of cells that is surrounded by a fibrous capsule. The term adenoma is used as this is a benign epithelial proliferation.
embryonic origins of adrenal medulla
neural crest


the pineal gland
3rd ventricle
regulates circadian rhythm, may also influce onset of gonadal development
“brain said” concretions useful in CT

germinal center
Parathyroid adenoma
identified due to excess hormone secretion (not mass effect)
cell appearance is very close to normal
usually benign
excess hormone may increase blood Ca and bone tunrover


pancreas
How to differentiate zones of the cortex of the adrenal gland?
The zona fasiculata is much more pale staining and you see empty space here. The zona fasciculata cells have lipid components and this is extracted during staining. This is why it looks white. But these cells are also much more puffy looking compared to the cells around them. And finally over here is the zona reticularis.
In the zona fasciculata the cells are in straight cords, in the reticularis you can see much more branching rather than straight lines.


interlobular duct
Thyroid follicle epithelium?
simple cuboidal

What are the 3 classes of hormones?
- steroids
- peptides, polypeptides, proteins
- AA, arachidonic acid analogs and derivatives
parathyroid

Oxyphil cell.